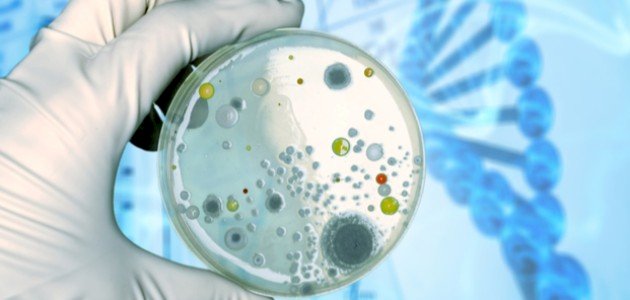
ما هي أشكال البكتيريا ما هي أشكال البكتيريا

محتويات
البكتيريا هي ميكروبات وحيدة الخلية، حيث تكون بنية الخلية فيها أبسط من تلك الموجودة في الكائنات الحية الأخرى، وتصنّف البكتيريا إلى مجموعات وفقًا لأشكالها الأساسية: مكوّة، وعصويّة، وحلزونية، وبكتيريا الضمّة، وتتواجد كخلايا مفردة، أو تعيش في أزواج، أو سلاسل، أو مجموعات،[١] وفيما يأتي توضيح لأشكالها:
البكتيريا المكورّة (بالإنجليزيّة: Coccus Bacteria) هي بكتيريا كرويّة أو بيضويّة الشّكل، وهي أبسط وأصغر أنواع البكتيريا، إذ يتراوح متوسط قطرها بين 0.5-1.0 ميكرومتر، وتنتمي إليها العديد من البكتيريا المسببّة للأمراض مثل البكتيريا التي تسبّب التهاب الحلق، والحمى القرمزيّة، والتّسمّم الغذائي، ومتلازمة الصّدمة التّسمميّة،[٢] وتترتب البكتيريا المكورة بعد انقسامها بعدة أنماط وهي:[٣]
- المكورات المزدوجة
(بالإنجليزيّة: Diplococci)، وهي مكورات تترتّب على شكل أزواج بعد الانقسام.
- المكورات العقديّة أو السّبحيّة
(بالإنجليزيّة: Streptococci)، بكتيريا مكورة تترتب على شكل سلاسل بعد الانقسام.
- المكورات الرّباعيّة
(بالإنجليزيّة: Tetrad)، بكتيريا مكورة تترتب على شكل مجموعات تتكوّن كل منها من أربع خلايا بكتيريّة، وتنقسم على مستويين.
- المكورات الرّزميّة
(بالإنجليزيّة: Sarcinae)، بكتيريا مكورّة تترتب على شكل مجموعات تتكوّن كل منها من 8 خلايا بكتيريّة، وتنقسم على ثلاثة مستويات.
- المكورات العنقوديّة
(بالإنجليزيّة: Staphylococci)، بكتيريا مكورة تترتب على شكل عناقيد، وتنقسم على عدة مستويات.
تعد البكتيريا العصويّة (بالإنجليزيّة: Bacillus) من البكتيريا موجبة غرام، يصل طول أكبر أنواعها وهي العصويّة الضّارية (الاسم العلمي: B. Megaterium) إلى 4 ميكرومتر، أمّا عرضها فيبلغ 1.5 ميكرومتر، ولا تسبب معظم سلالات البكتيريا العصويّة الأمراض للبشر، إلّا أنّ أحد أنواعها وهي العصويّة الجمريّة (الاسم العلمي: B. anthracis) تسبب مرض الجمرة الخبيثة للبشر والحيوانات.
بالإضافة إلى بعض الأنواع مثل البكتيريا العصويّة الشّمعيّة (الاسم العلمي: Bacillus Cereus) التي تسبّب تلف الأغذية المعلبة، والتسمم الغذائي لفترة قصيرة.[٤]
البكتيريا الحلزونيّة (بالإنجليزيّة: Spirilla Bacteria) هي خلايا بكتيريّة ملتفّة بشكل حلزوني أو لولبي، ومن أشكالها:[٣]
- البكتيريا الحليزينية
(بالإنجليزية: Spirillum Bacteria)، بكتيريا حلزونيّة ممدودة، لها سوط يُستخدم في الحركة، ومن الأمثلة عليها البكتيريا المعروفة علمياً باسم (Spirillum Minus)، والتي تسبب مرض حمى عضة الجرذ.
- البكتيريا الملتويّة
(بالإنجليزيّة: Spirochetes Bacteria)، خلايا بكتيريّة ملفوفة بإحكام، ومن الأمثلة عليها بكتيريا بوريليا برغدورفيرية (الاسم العلمي: Borrelia Burgdorferi) التي تسبّب داء لايم.
بكتيريا الضّمة (بالإنجليزيّة: Vibrio Bacteria) هي بكتيريا تأخذ شكل المنحنى أو شكل الفاصلة، وهي من البكتيريا اللاهوائيّة الاختياريّة، ولها سوط يُمكنّها من الحركة، ومن الأمثلة عليها بكتيريا ضمة الكوليرا (الاسم العلمي: Vibrio Cholerae) التي تسبب مرض الكوليرا، وبعض أنواعها يسبب التّسمم الغذائي، وبعضها يهاجم الجروح المفتوحة ويسبب تسمّم الدّم.[٣]
تحتوي البكتيريا على أنوية خلايا البكتيريا بدائية، وهذا يعني عدم احتوائها على نوى منظمة، كما أنّ عضياتها غير محاطة بالغشاء، حيث إنّ الحمض النووي البكتيري يطفو بحرية داخل الخلايا البكتيرية وداخل كتلة ملتوية تشبه الخيوط تسمى النواة.[٥]
ويجدر بالذكر أنّ البكتيريا تتكوّن من الأجزاء الرئيسية الآتية:[٦]
- جدار الخلية
هو جدار خلوي صلب يحيط بالخلية، ويعطي الخلية شكلها ويحيط بالغشاء السيتوبلازمي، ويحميها مما حولها، كما أنّه يساعد على تثبيت الزوائد مثل الشعرة والسوط.
- غلاف الخلية
يتكون غلاف الخلية من طبقتين إلى ثلاث طبقات: الغشاء السيتوبلازمي الداخلي، وجدار الخلية، وفي بعض أنواع البكتيريا كبسولة خارجية.
- الكبسولة
تحتوي بعض أنواع البكتيريا على غطاء واقي ثالث يسمّى الكبسولة، ويتكون من السكريات، حيث يمنع البكتيريا من الجفاف ويحميها من الابتلاع بواسطة الكائنات الحية الدقيقة الأكبر حجمًا.
- السيتوبلازم
يُشبه الهلام، ويتكون من الماء، والإنزيمات، والعناصر الغذائية، والنفايات، والغازات، كما يحتوي على هياكل خلوية، مثل الريبوسومات، والكروموسوم، والبلازميدات، وهو المكان الذي تُنفّذ فيه وظائف نمو الخلايا، والتمثيل الغذائي، والتكاثر.
- البلازميدات
عبارة عن تراكيب وراثية صغيرة، تحملها سلالات عديدة من البكتيريا، مثل الكروموسوم، وتتكون البلازميدات من قطعة دائرية من الحمض النووي.
- الغشاء السيتوبلازمي
وهو طبقة من الدهون الفوسفورية والبروتينات، يحيط بالبكتيريا الداخلية، وتنظم تدفق المواد داخل وخارج الخلية.
- السوط
وهي هياكل تشبه الشعر، وتوفر وسيلة تنقل البكتيريا التي تحتوي عليها، ويمكن تواجدها في أحد طرفي البكتيريا، أو تنتشر على كل سطحها.
- نوكليويد
هي منطقة من السيتوبلازم حيث توجد خيوط الحمض النووي.
- بيلوس
وهي نتوءات صغيرة تشبه الشعر، تنبثق من سطح الخلية الخارجي، وتساعد البكتيريا على الالتصاق بالخلايا والأسطح الأخرى، مثل الأسنان، والأمعاء، والصخور.
- الريبوسومات
هي مصانع مجهرية موجودة في جميع الخلايا، وتترجم الشفرة الجينية.
- ↑ microbiologysociety team (2021), “BACTERIA”, microbiologysociety, Retrieved 27/10/2021. Edited.
- ↑ Lynette Arceneaux; (25-4-2018), “The 3 Types of Bacteria”، sciencing.com, Retrieved 5-5-2019. Edited.
- ^ أ ب ت Regina Bailey (13-12-2018), “Bacteria Shapes”، www.thoughtco.com, Retrieved 5-5-2019. Edited.
- ↑ “Bacillus”, www.britannica.com, Retrieved 5-5-2019. Edited.
- ↑ Aparna Vidyasagar (4/10/2020), “What are bacteria?”, livescience, Retrieved 27/10/2021. Edited.
- ↑ micro team (13/11/2015), “Bacteria Cell Structure”, micro, Retrieved 27/10/2021. Edited.










